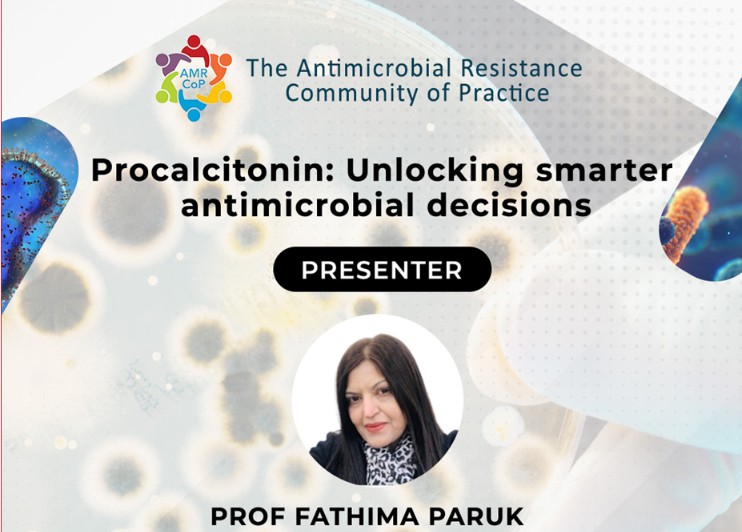
AMR CoP ECHO Session

In this session, we explore how Procalcitonin — a key diagnostic biomarker — can be harnessed as a precision tool to guide antibiotic initiation, duration, and de-escalation, ultimately supporting more effective antimicrobial stewardship across clinical settings.